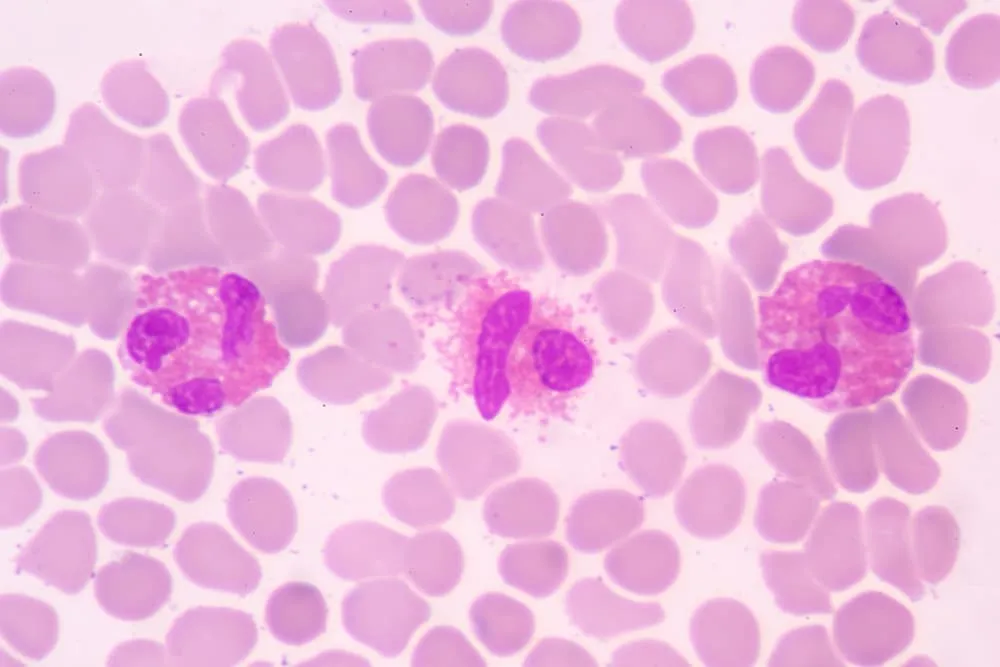
Granulocyty pod mikroskopem

Podwyższony poziom granulocytów w badaniu krwi, znany w medycynie jako granulocytoza, to wynik, który często budzi niepokój. Zrozumienie, co dokładnie oznacza ten parametr, jest kluczowe, ponieważ może on sygnalizować zarówno przejściowe i niegroźne stany, jak i poważniejsze schorzenia wymagające pilnej interwencji. Właśnie dlatego postanowiłem szczegółowo omówić to zagadnienie, aby pomóc Ci zinterpretować Twój wynik i wskazać, kiedy konieczna jest wizyta u specjalisty.
Podwyższone granulocyty co to znaczy i kiedy wymaga uwagi lekarza?
- Granulocyty to kluczowe białe krwinki układu odpornościowego, dzielące się na neutrofile, eozynofile i bazofile.
- Podwyższony poziom granulocytów (granulocytoza) może być spowodowany przez wiele czynników, od stresu i infekcji po choroby przewlekłe i nowotworowe.
- Najczęstszymi przyczynami granulocytozy są infekcje bakteryjne i stany zapalne.
- Zrozumienie norm oraz różnic między poszczególnymi typami granulocytów jest kluczowe dla interpretacji wyników.
- Obecność niedojrzałych form granulocytów (IG) we krwi obwodowej, czyli "przesunięcie w lewo", zawsze wymaga dokładnej analizy.
- Każdy nieprawidłowy wynik morfologii krwi, w tym podwyższone granulocyty, wymaga konsultacji z lekarzem w celu dalszej diagnostyki i ustalenia przyczyny.
Granulocyty, czyli kto? Poznaj cichych strażników Twojej odporności
Granulocyty to niezwykle ważny rodzaj białych krwinek, czyli leukocytów, które stanowią pierwszą linię obrony Twojego organizmu przed różnego rodzaju zagrożeniami. Są one kluczowym elementem wrodzonego układu odpornościowego i pełnią funkcję "żołnierzy", którzy szybko reagują na infekcje i stany zapalne. Wyróżniamy trzy główne typy granulocytów, z których każdy ma swoją specyficzną rolę: neutrofile (granulocyty obojętnochłonne) są najliczniejsze i odpowiadają głównie za walkę z bakteriami, eozynofile (granulocyty kwasochłonne) są kluczowe w obronie przed pasożytami i w reakcjach alergicznych, natomiast bazofile (granulocyty zasadochłonne) biorą udział w reakcjach alergicznych i zapalnych, uwalniając histaminę.

Jak odczytać swoje wyniki? Normy granulocytów, które warto znać
Kiedy otrzymujesz wyniki morfologii krwi, możesz poczuć się zagubiony w gąszczu liczb i skrótów. Pamiętaj, że normy dla poszczególnych typów granulocytów mogą się nieznacznie różnić w zależności od laboratorium, dlatego zawsze warto sprawdzić zakres referencyjny podany na Twoim wydruku. Poniżej przedstawiam orientacyjne wartości, które pomogą Ci wstępnie zorientować się w Twoich wynikach:
| Typ granulocytów | Norma |
|---|---|
| Neutrofile (granulocyty obojętnochłonne) | 1800-8000/µl (ok. 50-70% wszystkich leukocytów) |
| Eozynofile (granulocyty kwasochłonne) | 50-400/µl (ok. 2-4% wszystkich leukocytów) |
| Bazofile (granulocyty zasadochłonne) | 0-300/µl (ok. 0-1% wszystkich leukocytów) |
Dlaczego wynik jest powyżej normy? Przegląd możliwych scenariuszy
Stan, w którym poziom granulocytów jest podwyższony, nazywamy granulocytozą. To ważne, aby zrozumieć, że nie jest to diagnoza sama w sobie, lecz sygnał, że w organizmie dzieje się coś, co wymaga uwagi. Przyczyny granulocytozy są niezwykle zróżnicowane od zupełnie błahych, fizjologicznych reakcji, po poważne schorzenia, które wymagają natychmiastowej interwencji medycznej. W kolejnych sekcjach szczegółowo omówię te scenariusze, abyś mógł lepiej zrozumieć swój wynik.
Granulocytoza czy styl życia wpływa na wyniki?
Często zapominamy, że nasze codzienne nawyki i przeżycia mogą mieć realny wpływ na wyniki badań laboratoryjnych. Podwyższony poziom granulocytów nie zawsze oznacza chorobę czasem jest to po prostu odpowiedź organizmu na czynniki zewnętrzne.
Stres, wysiłek, papieros jak codzienne nawyki podnoszą poziom granulocytów
- Reakcje na stres fizjologiczny: Organizm reaguje na różnego rodzaju "stresory" fizyczne, takie jak urazy, oparzenia, niedawno przebyte zabiegi operacyjne czy nawet zawał serca, zwiększając produkcję granulocytów. To naturalna odpowiedź, mająca na celu przygotowanie organizmu do walki z potencjalnymi infekcjami lub naprawy uszkodzonych tkanek.
- Intensywny wysiłek fizyczny: Po bardzo intensywnym treningu lub wysiłku fizycznym, poziom granulocytów może być przejściowo podwyższony. Jest to związane z aktywacją układu odpornościowego i uwalnianiem komórek z rezerw.
- Silny stres psychiczny: Przewlekły lub bardzo silny stres emocjonalny również może wpływać na układ odpornościowy, prowadząc do wzrostu liczby białych krwinek, w tym granulocytów.
- Palenie papierosów: Jest to jeden z najczęstszych czynników niezwiązanych z chorobami, który trwale podnosi poziom granulocytów. Substancje toksyczne zawarte w dymie tytoniowym wywołują przewlekły stan zapalny w drogach oddechowych, co stymuluje szpik kostny do zwiększonej produkcji tych komórek.
Granulocyty w ciąży kiedy podwyższony poziom jest zjawiskiem naturalnym?
Ciąża to wyjątkowy czas w życiu kobiety, a organizm przechodzi wtedy wiele adaptacyjnych zmian. Jedną z nich jest fizjologiczny wzrost liczby białych krwinek, w tym granulocytów. Podwyższony poziom tych komórek, a nawet obecność niewielkiej ilości niedojrzałych form, jest w ciąży często zjawiskiem naturalnym i nie powinien budzić nadmiernego niepokoju. Jest to element przygotowania organizmu do ochrony zarówno matki, jak i rozwijającego się płodu.
Kiedy podwyższone granulocyty to sygnał alarmowy?
Choć niektóre przyczyny granulocytozy są niegroźne, musimy być świadomi, że podwyższone granulocyty mogą być również sygnałem poważniejszych problemów zdrowotnych. W takich sytuacjach szybka i trafna diagnoza jest kluczowa.
Infekcje bakteryjne i wirusowe wróg numer jeden Twojego układu odpornościowego
Najczęstszą przyczyną podwyższonego poziomu granulocytów, a zwłaszcza neutrofili, są infekcje. Kiedy do organizmu wnikają patogeny, takie jak bakterie, wirusy, grzyby czy pasożyty, układ odpornościowy mobilizuje swoje siły. Neutrofile, jako pierwsza linia obrony, szybko migrują do miejsca infekcji, aby zwalczyć intruza. Dlatego też wysoki poziom granulocytów często towarzyszy zapaleniu płuc, zapaleniu wyrostka robaczkowego, anginie, infekcjom dróg moczowych czy innym ostrym stanom zapalnym. W przypadku infekcji wirusowych, choć początkowo może dominować limfocytoza, w niektórych fazach choroby również obserwuje się wzrost granulocytów.
Choroby przewlekłe i stany zapalne: od alergii po reumatoidalne zapalenie stawów
- Przewlekłe choroby zapalne: Wiele chorób autoimmunologicznych i przewlekłych stanów zapalnych, takich jak reumatoidalne zapalenie stawów, toczeń rumieniowaty układowy czy wrzodziejące zapalenie jelita grubego, charakteryzuje się podwyższonym poziomem granulocytów. Jest to wynik ciągłej aktywacji układu odpornościowego w odpowiedzi na proces zapalny toczący się w organizmie.
- Choroby alergiczne: W przypadku alergii, takich jak astma oskrzelowa, katar sienny czy atopowe zapalenie skóry, często obserwujemy podwyższony poziom eozynofili (eozynofilia). Te granulocyty odgrywają kluczową rolę w reakcjach nadwrażliwości i ich wzrost jest typowym wskaźnikiem aktywnej alergii.
- Inne przyczyny: Do wzrostu granulocytów mogą przyczynić się również niektóre choroby metaboliczne, takie jak kwasica ketonowa w cukrzycy, a także zatrucia czy stosowanie niektórych leków, np. glikokortykosteroidów.
Kiedy myśleć o najgorszym? Rola granulocytów w diagnostyce chorób hematologicznych i nowotworowych
Chociaż są to rzadsze przyczyny, nie można pominąć roli podwyższonych granulocytów w diagnostyce poważniejszych schorzeń, w tym chorób hematologicznych i nowotworowych. Znaczący i utrzymujący się wzrost liczby granulocytów, szczególnie w połączeniu z innymi nieprawidłowościami w morfologii krwi, może być sygnałem ostrzegawczym. Przykładem jest przewlekła białaczka szpikowa, gdzie obserwuje się drastyczny wzrost liczby granulocytów. Inne nowotwory, nawet te niezwiązane bezpośrednio ze szpikiem kostnym, mogą również stymulować produkcję białych krwinek. W takich przypadkach konieczna jest pogłębiona diagnostyka, aby wykluczyć lub potwierdzić te poważne schorzenia.

Podwyższone neutrofile, eozynofile i bazofile co oznaczają?
Zrozumienie, który konkretnie typ granulocytów jest podwyższony, to klucz do zawężenia listy potencjalnych przyczyn. Każdy z nich ma swoją "specjalizację".
Neutrofilia: co oznacza dominacja granulocytów obojętnochłonnych?
Neutrofilia to stan, w którym liczba neutrofili (granulocytów obojętnochłonnych) we krwi jest podwyższona. To najczęściej spotykany typ granulocytozy i zazwyczaj wskazuje na obecność ostrej infekcji bakteryjnej lub stanu zapalnego w organizmie. Neutrofilia może być również wywołana przez stres fizyczny (np. urazy, oparzenia, operacje), a także przez stosowanie niektórych leków, w tym popularnych glikokortykosteroidów. Ich dominacja to sygnał, że układ odpornościowy aktywnie walczy z zagrożeniem.
Eozynofilia: czy to znak, że Twoim problemem są alergie lub pasożyty?
Eozynofilia, czyli podwyższony poziom eozynofili (granulocytów kwasochłonnych), jest silnie związana z dwoma głównymi grupami problemów zdrowotnych. Po pierwsze, jest to typowy wskaźnik reakcji alergicznych, takich jak astma oskrzelowa, katar sienny, atopowe zapalenie skóry czy alergie pokarmowe. Po drugie, eozynofile odgrywają kluczową rolę w obronie przed infekcjami pasożytniczymi. Jeśli więc Twój wynik wskazuje na eozynofilię, lekarz z pewnością będzie dążył do wykluczenia alergii lub obecności pasożytów.
Bazofilia: rzadki wynik, który może wskazywać na stany zapalne lub problemy z tarczycą
Bazofilia, czyli podwyższony poziom bazofili (granulocytów zasadochłonnych), jest znacznie rzadziej spotykanym wynikiem niż neutrofilia czy eozynofilia. Kiedy jednak się pojawia, może wskazywać na przewlekłe stany zapalne, takie jak wrzodziejące zapalenie jelita grubego, ale także na problemy z tarczycą, w szczególności na niedoczynność tarczycy. W niektórych przypadkach bazofilia może być również związana z chorobami mieloproliferacyjnymi, dlatego zawsze wymaga dokładnej analizy.
Niedojrzałe granulocyty (IG) i "przesunięcie w lewo" w wynikach.
W wynikach morfologii krwi możesz czasem natknąć się na informację o obecności niedojrzałych granulocytów (IG) lub o "przesunięciu w lewo". To bardzo ważny wskaźnik, który świadczy o intensywnej pracy szpiku kostnego.
Dlaczego szpik kostny wysyła "rekrutów" do walki?
Niedojrzałe granulocyty (IG) to formy granulocytów, które normalnie dojrzewają w szpiku kostnym i dopiero w pełni dojrzałe są uwalniane do krwi obwodowej. Ich obecność we krwi, zwłaszcza w większej liczbie, nazywana jest "przesunięciem w lewo" w rozmazie krwi. Oznacza to, że szpik kostny jest tak silnie stymulowany do produkcji białych krwinek często w odpowiedzi na poważne zagrożenie, takie jak ciężka infekcja że nie nadąża z ich pełnym dojrzewaniem i "wysyła do walki" również młodsze, niedojrzałe formy. To jak wysłanie rekrutów na front, gdy brakuje doświadczonych żołnierzy.
Jak interpretować obecność niedojrzałych form granulocytów w kontekście innych badań?
Obecność niedojrzałych form granulocytów (IG) zawsze wymaga uwagi. Chociaż, jak wspomniałem, może być zjawiskiem fizjologicznym, na przykład w ciąży, to ich znacząca ilość, szczególnie w połączeniu z innymi nieprawidłowymi parametrami krwi (np. bardzo wysoką gorączką, spadkiem ciśnienia krwi, zmianami w innych liniach komórkowych), wymaga pilnej i kompleksowej oceny medycznej. Może to być sygnał poważnych stanów, takich jak sepsa (ogólnoustrojowa reakcja zapalna na infekcję) czy nawet białaczka. W takich sytuacjach niezbędne są dalsze badania i szybka diagnoza, aby podjąć odpowiednie leczenie.
Co dalej po otrzymaniu nieprawidłowego wyniku granulocytów?
Otrzymanie wyniku odbiegającego od normy może być stresujące, ale pamiętaj, że to dopiero początek drogi diagnostycznej. Najważniejsze jest podjęcie odpowiednich kroków.
Dlaczego konsultacja z lekarzem jest absolutnie kluczowa?
Chciałbym to bardzo mocno podkreślić: konsultacja z lekarzem po otrzymaniu wyniku wskazującego na podwyższony poziom granulocytów jest absolutnie kluczowa i nie można jej lekceważyć. Tylko lekarz, posiadający pełną wiedzę o Twoim stanie zdrowia, historii chorób, przyjmowanych lekach i ewentualnych objawach, jest w stanie prawidłowo zinterpretować te wyniki. Samodzielna interpretacja, oparta jedynie na informacjach z internetu, może prowadzić do błędnych wniosków i niepotrzebnego stresu lub, co gorsza, do zbagatelizowania poważnego problemu. Lekarz oceni całościowy obraz kliniczny i zdecyduje o dalszych krokach.
Jakie dodatkowe badania może zlecić lekarz, aby znaleźć przyczynę?
W zależności od wstępnej oceny i podejrzewanej przyczyny, lekarz może zlecić szereg dodatkowych badań, aby dokładnie zdiagnozować źródło granulocytozy. Mogą to być:
- Badania laboratoryjne: Takie jak CRP (białko C-reaktywne) i OB (odczyn Biernackiego) do oceny stanu zapalnego, posiewy krwi, moczu, plwociny w przypadku podejrzenia infekcji, badania serologiczne w kierunku wirusów czy pasożytów, a także bardziej szczegółowe badania hematologiczne, w tym rozmaz krwi obwodowej czy biopsja szpiku kostnego.
- Badania obrazowe: Rentgen klatki piersiowej, USG jamy brzusznej, tomografia komputerowa czy rezonans magnetyczny, jeśli podejrzewa się obecność ognisk zapalnych, guzów lub innych zmian strukturalnych w narządach.
- Konsultacje specjalistyczne: W zależności od podejrzewanej przyczyny, lekarz może skierować Cię do hematologa, alergologa, reumatologa, pulmonologa czy innego specjalisty.
Przeczytaj również: Podwyższony poziom cukru: Co oznacza i jak go skutecznie obniżyć?
Leczenie przyczyny, a nie objawu na czym polega terapia w przypadku granulocytozy?
Ważne jest, aby pamiętać, że granulocytoza sama w sobie nie jest chorobą, lecz objawem. Dlatego też leczenie nie polega na obniżaniu samej liczby granulocytów, ale na zidentyfikowaniu i wyeliminowaniu pierwotnej przyczyny, która doprowadziła do ich podwyższonego poziomu. Jeśli przyczyną jest infekcja bakteryjna, zastosowana zostanie antybiotykoterapia. W przypadku chorób zapalnych, lekarz wdroży leki przeciwzapalne lub immunosupresyjne. Jeśli granulocytoza jest wynikiem choroby nowotworowej, konieczne będzie specyficzne leczenie onkologiczne. Terapia jest zawsze dostosowana do indywidualnej sytuacji pacjenta i podstawowej diagnozy.

